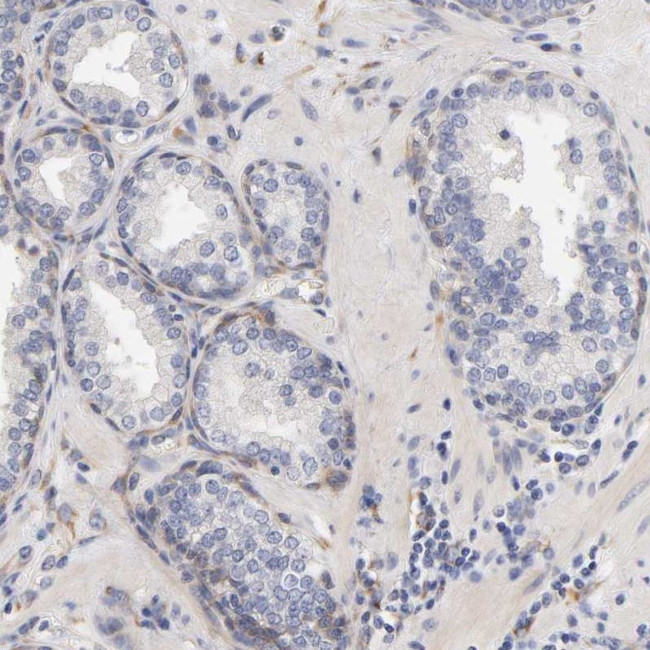
Laminin beta-1 Antibody in Immunohistochemistry (Paraffin) (IHC (P))

Search
Invitrogen
Laminin beta-1 Polyclonal Antibody
{{$productOrderCtrl.translations['antibody.pdp.commerceCard.promotion.promotions']}}
{{$productOrderCtrl.translations['antibody.pdp.commerceCard.promotion.viewpromo']}}
{{$productOrderCtrl.translations['antibody.pdp.commerceCard.promotion.promocode']}}: {{promo.promoCode}} {{promo.promoTitle}} {{promo.promoDescription}}. {{$productOrderCtrl.translations['antibody.pdp.commerceCard.promotion.learnmore']}}
产品信息
PA5-82138
种属反应
宿主/亚型
分类
类型
抗原
偶联物
形式
浓度
规格
纯化类型
保存液
内含物
保存条件
运输条件
RRID
产品详细信息
Immunogen sequence: NQVVSLSPGS RYVVLPRPVC FEKGTNYTVR LELPQYTSSD SDVESPYTLI DSLVLMPYCK SLDIFTVGGS GDGVVTNSAW ETFQRYRCLE NSRSVVKTPM TDVCRNIIFS ISALLHQTGL ACECDPQGSL SSVCDPNGG
Highest antigen sequence indentity to the following orthologs: Rat - 96%, Mouse - 96%.
靶标信息
Laminins are large heterotrimeric, noncollagenous glycoproteins composed of alpha, beta, and gamma chains. They are ubiquitously present in basement membrane (BM) along with entactin/nidogen (EN), collagen type IV (CIV), and large heparan sulfate proteoglycan (HSPG), which interact specifically with each other to form a continuous and regular BM. Alterations of BM integrity, from local discontinuities up to complete loss, are described in many types of human and animal epithelial neoplasms.
仅用于科研。不用于诊断过程。未经明确授权不得转售。
篇参考文献 (0)
生物信息学
蛋白别名: laminin B1; Laminin B1 chain; laminin beta 1; Laminin subunit beta-1; laminin, beta 1; Laminin-1 subunit beta; Laminin-10 subunit beta; Laminin-12 subunit beta; Laminin-2 subunit beta; Laminin-6 subunit beta; Laminin-8 subunit beta; MGC142015; unnamed protein product
基因别名: CLM; LAMB1; LIS5
UniProt ID: (Human) P07942
Entrez Gene ID: (Human) 3912